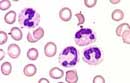

Kurzbeschreibung:
Unter Linksverschiebung versteht man eine relative Vermehrung der stabkernigen Neutrophilen gegenüber den segmentkernigen Neutrophilen. Normalerweise beträgt das Verhältnis rund 1 : 4 (Fadenregel), bzw. 1 : 12-15 (Drittelsregel ). Als toxisch werden die typischerweise im Rahmen von schweren bakteriellen Infekten vorkommenden Veränderungen der Neutrophilen wie toxische Granulationen, Vakuolen und basophile Schlieren (Döhle Körperchen) bezeichnet.
Klinisches Bild:
Die (toxische) Linksverschiebung ist kein Krankheitsbild sondern ein deskriptiv-morphologischer Begriff. Diese Blutbildveränderung kommt in der Regel im Rahmen von bakteriellen Infekten vor, aber auch bei anderen Situationen wie Verbrennungen, Tumorzerfall oder akuten Entzündungen (z.B. Gichtanfall).
Hämatologie:
Meist besteht eine Leukozytose mit